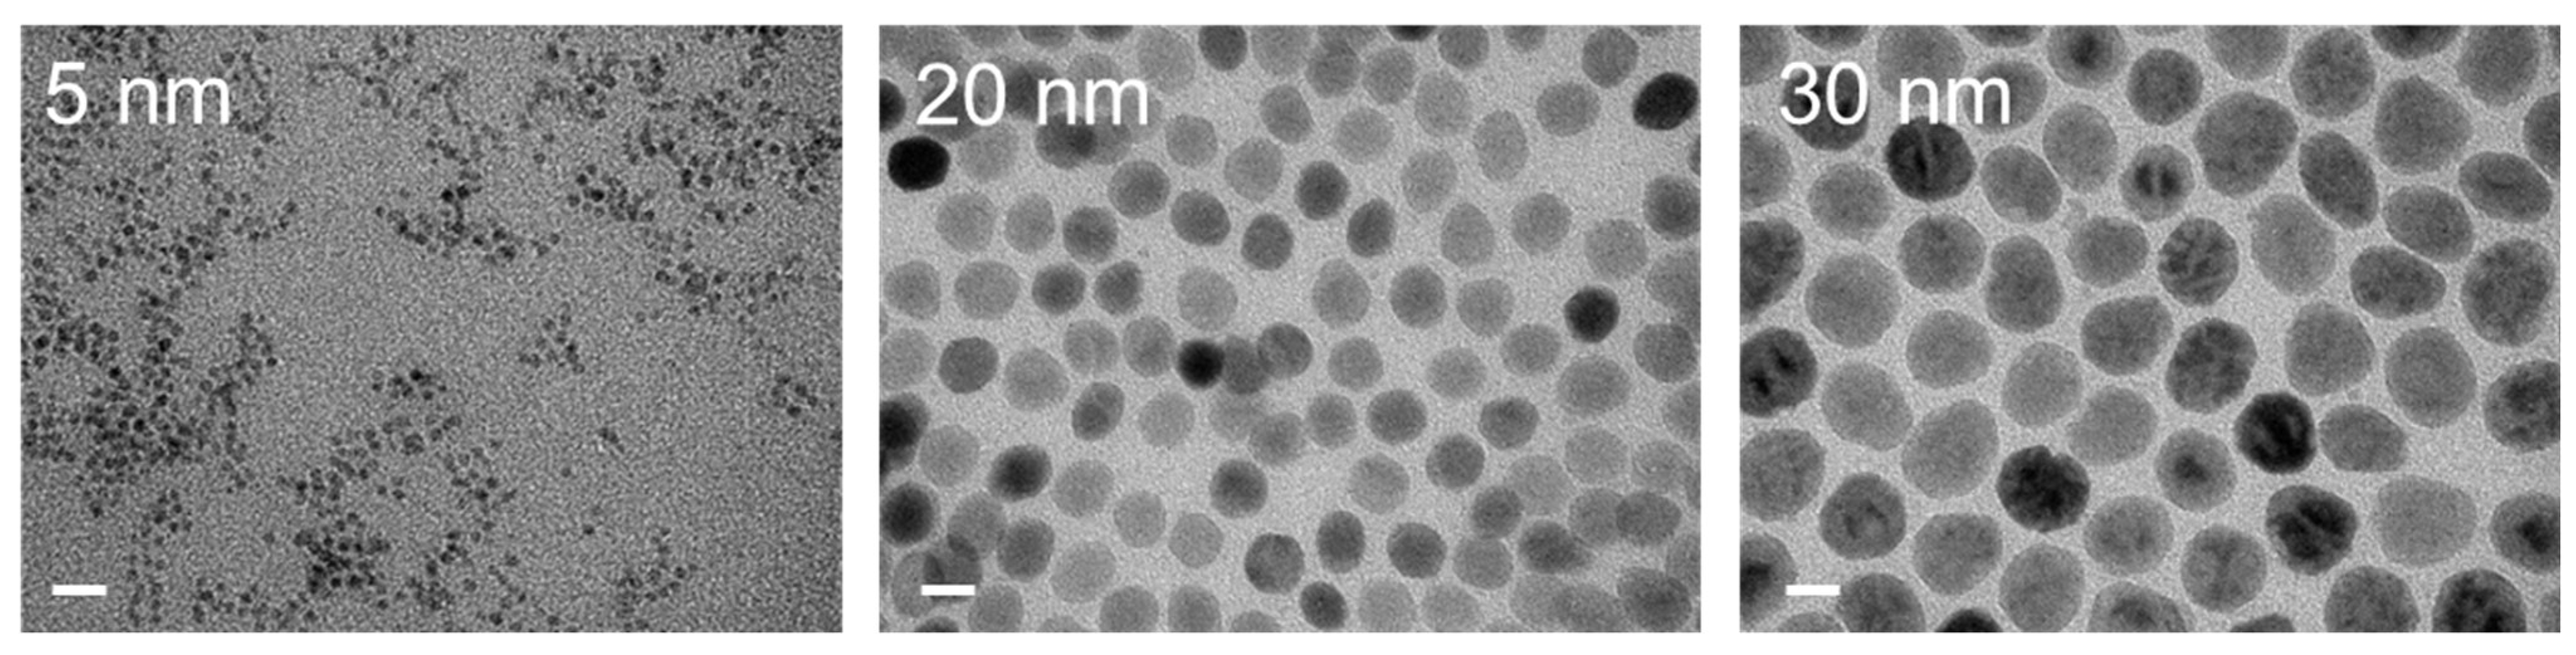

Synergistic Effect of Repolarization of M2 to M1 Macrophages Induced by Iron Oxide Nanoparticles Combined with Lactate Oxidase
Abstract
:1. Introduction
2. Results
2.1. Macrophages Incubated with Iron Oxide Nanoparticles Combined with LOX
2.2. Distribution of Macrophages with Various Treatments
2.3. Apoptosis Induced by M1 Macrophages
3. Discussion
4. Materials and Methods
4.1. Materials
4.2. Cell Culture and Polarization of M2 Macrophages
4.3. Cytotoxicity of Materials
4.4. Macrophages under Iron Oxide Nanoparticles Combined with LOX
4.5. Macrophage Staining Assay
5. Conclusions
Author Contributions
Funding
Institutional Review Board Statement
Informed Consent Statement
Data Availability Statement
Acknowledgments
Conflicts of Interest
References
- Yang, C.Y.; Yang, J.C.; Yang, P.C. Precision Management of Advanced Non-Small Cell Lung Cancer. Annu. Rev. Med. 2020, 71, 117–136. [Google Scholar] [CrossRef] [Green Version]
- Liao, Z.X.; Huang, K.Y.; Kempson, I.M.; Li, H.J.; Tseng, S.J.; Yang, P.C. Nanomodified strategies to overcome EGFR-tyrosine kinase inhibitors resistance in non-small cell lung cancer. J. Control. Release 2020, 324, 482–492. [Google Scholar] [CrossRef]
- Liao, Z.X.; Kempson, I.M.; Hsieh, C.C.; Tseng, S.J.; Yang, P.C. Potential therapeutics using tumor-secreted lactate in nonsmall cell lung cancer. Drug Discov. Today 2021, 26, 2508–2514. [Google Scholar] [CrossRef]
- Francis, D.M.; Thomas, S.N. Progress and opportunities for enhancing the delivery and efficacy of checkpoint inhibitors for cancer immunotherapy. Adv. Drug Deliv. Rev. 2017, 114, 33–42. [Google Scholar] [CrossRef] [Green Version]
- Ou, D.L.; Tseng, S.J.; Kempson, I.M.; Hsu, C.L.; Yang, P.C.; Liao, Z.X. Enhanced Targeting and Immune Activation of Tumor Microenvironment by Nanomodified Anti-PD1 in Liver Cancer. Adv. Ther. 2021, 4, 2100048. [Google Scholar] [CrossRef]
- Shields, C.W.; Evans, M.A.; Wang, L.L.W.; Baugh, N.; Iyer, S.; Wu, D.; Zhao, Z.; Pusuluri, A.; Ukidve, A.; Pan, D.C.; et al. Cellular backpacks for macrophage immunotherapy. Sci. Adv. 2020, 6, eaaz6579. [Google Scholar] [CrossRef]
- Xiao, L.; Shiwaku, Y.; Hamai, R.; Tsuchiya, K.; Sasaki, K.; Suzuki, O. Macrophage Polarization Related to Crystal Phases of Calcium Phosphate Biomaterials. Int. J. Mol. Sci. 2021, 22, 11252. [Google Scholar] [CrossRef]
- Faubert, B.; Li, K.Y.; Cai, L.; Hensley, C.T.; Kim, J.; Zacharias, L.G.; Yang, C.; Do, Q.N.; Doucette, S.; Burguete, D.; et al. Lactate Metabolism in Human Lung Tumors. Cell 2017, 171, 358–371.e9. [Google Scholar] [CrossRef] [PubMed] [Green Version]
- Tseng, S.J.; Kempson, I.M.; Huang, K.Y.; Li, H.J.; Fa, Y.C.; Ho, Y.C.; Liao, Z.X.; Yang, P.C. Targeting Tumor Microenvironment by Bioreduction-Activated Nanoparticles for Light-Triggered Virotherapy. ACS Nano 2018, 12, 9894–9902. [Google Scholar] [CrossRef]
- Tu, V.Y.; Ayari, A.; O’Connor, R.S. Beyond the Lactate Paradox: How Lactate and Acidity Impact T Cell Therapies against Cancer. Antibodies 2021, 10, 25. [Google Scholar] [CrossRef] [PubMed]
- Wang, J.X.; Choi, S.Y.C.; Niu, X.; Kang, N.; Xue, H.; Killam, J.; Wang, Y. Lactic Acid and an Acidic Tumor Microenvironment suppress Anticancer Immunity. Int. J. Mol. Sci. 2020, 21, 8363. [Google Scholar] [CrossRef] [PubMed]
- Zanganeh, S.; Hutter, G.; Spitler, R.; Lenkov, O.; Mahmoudi, M.; Shaw, A.; Pajarinen, J.S.; Nejadnik, H.; Goodman, S.; Moseley, M.; et al. Iron oxide nanoparticles inhibit tumour growth by inducing pro-inflammatory macrophage polarization in tumour tissues. Nat. Nanotechnol. 2016, 11, 986–994. [Google Scholar] [CrossRef] [PubMed]
- Aldawsari, M.F.; Alalaiwe, A.; Khafagy, E.S.; Al Saqr, A.; Alshahrani, S.M.; Alsulays, B.B.; Alshehri, S.; Abu Lila, A.S.; Danish Rizvi, S.M.; Hegazy, W.A.H. Efficacy of SPG-ODN 1826 Nanovehicles in Inducing M1 Phenotype through TLR-9 Activation in Murine Alveolar J774A.1 Cells: Plausible Nano-Immunotherapy for Lung Carcinoma. Int. J. Mol. Sci. 2021, 22, 6833. [Google Scholar] [CrossRef]
- Wang, Z.; He, X.; Chen, S.; He, C.; Wang, T.; Mao, X. Recent Advances in Metal-Based Magnetic Composites as High-Efficiency Candidates for Ultrasound-Assisted Effects in Cancer Therapy. Int. J. Mol. Sci. 2021, 22, 10461. [Google Scholar] [CrossRef]
- Gu, Z.; Liu, T.; Tang, J.; Yang, Y.; Song, H.; Tuong, Z.K.; Fu, J.; Yu, C. Mechanism of Iron Oxide-Induced Macrophage Activation: The Impact of Composition and the Underlying Signaling Pathway. J. Am. Chem. Soc. 2019, 141, 6122–6126. [Google Scholar] [CrossRef] [PubMed]
- Liao, Z.X.; Fa, Y.C.; Kempson, I.M.; Tseng, S.J. Repolarization of M2 to M1 Macrophages Triggered by Lactate Oxidase Released from Methylcellulose Hydrogel. Bioconjugate Chem. 2019, 30, 2697–2702. [Google Scholar] [CrossRef]
- Bolandi, N.; Derakhshani, A.; Hemmat, N.; Baghbanzadeh, A.; Asadzadeh, Z.; Afrashteh Nour, M.; Brunetti, O.; Bernardini, R.; Silvestris, N.; Baradaran, B. The Positive and Negative Immunoregulatory Role of B7 Family: Promising Novel Targets in Gastric Cancer Treatment. Int. J. Mol. Sci. 2021, 22, 10719. [Google Scholar] [CrossRef]
- Groux-Degroote, S.; Delannoy, P. Cancer-Associated Glycosphingolipids as Tumor Markers and Targets for Cancer Immunotherapy. Int. J. Mol. Sci. 2021, 22, 6145. [Google Scholar] [CrossRef]
- Koukourakis, M.I.; Giatromanolaki, A. Warburg effect, lactate dehydrogenase, and radio/chemo-therapy efficacy. Int. J. Radiat. Biol. 2019, 95, 408–426. [Google Scholar] [CrossRef]
- Brand, A.; Singer, K.; Koehl, G.E.; Kolitzus, M.; Schoenhammer, G.; Thiel, A.; Matos, C.; Bruss, C.; Klobuch, S.; Peter, K.; et al. LDHA-Associated Lactic Acid Production Blunts Tumor Immunosurveillance by T and NK Cells. Cell Metab. 2016, 24, 657–671. [Google Scholar] [CrossRef] [Green Version]
- Zhang, S.L.; He, Y.; Tam, K.Y. Targeting cancer metabolism to develop human lactate dehydrogenase (hLDH)5 inhibitors. Drug Discov. Today 2018, 23, 1407–1415. [Google Scholar] [CrossRef] [PubMed]
- Halford, S.E.R.; Jones, P.; Wedge, S.; Hirschberg, S.; Katugampola, S.; Veal, G.; Payne, G.; Bacon, C.; Potter, S.; Griffin, M.; et al. A first-in-human first-in-class (FIC) trial of the monocarboxylate transporter 1 (MCT1) inhibitor AZD3965 in patients with advanced solid tumours. J. Clin. Oncol. 2017, 35, 2516. [Google Scholar] [CrossRef]
- Quanz, M.; Bender, E.; Kopitz, C.; Grunewald, S.; Schlicker, A.; Schwede, W.; Eheim, A.; Toschi, L.; Neuhaus, R.; Richter, C.; et al. Preclinical Efficacy of the Novel Monocarboxylate Transporter 1 Inhibitor BAY-8002 and Associated Markers of Resistance. Mol. Cancer Ther. 2018, 17, 2285–2296. [Google Scholar] [CrossRef] [PubMed] [Green Version]
- Tang, J.; Meka, A.K.; Theivendran, S.; Wang, Y.; Yang, Y.; Song, H.; Fu, J.; Ban, W.; Gu, Z.; Lei, C.; et al. Openwork@Dendritic Mesoporous Silica Nanoparticles for Lactate Depletion and Tumor Microenvironment Regulation. Angew. Chem. Int. Ed. Engl. 2020, 59, 22054–22062. [Google Scholar] [CrossRef] [PubMed]
- Zhou, X.; Zhao, W.; Wang, M.; Zhang, S.; Li, Y.; Hu, W.; Ren, L.; Luo, S.; Chen, Z. Dual-Modal Therapeutic Role of the Lactate Oxidase-Embedded Hierarchical Porous Zeolitic Imidazolate Framework as a Nanocatalyst for Effective Tumor Suppression. ACS Appl. Mater. Interfaces 2020, 12, 32278–32288. [Google Scholar] [CrossRef] [PubMed]
- Shi, C.; Liu, T.; Guo, Z.; Zhuang, R.; Zhang, X.; Chen, X. Reprogramming Tumor-Associated Macrophages by Nanoparticle-Based Reactive Oxygen Species Photogeneration. Nano Lett. 2018, 18, 7330–7342. [Google Scholar] [CrossRef]
- Chauhan, A.; Khan, T.; Omri, A. Design and Encapsulation of Immunomodulators onto Gold Nanoparticles in Cancer Immunotherapy. Int. J. Mol. Sci. 2021, 22, 8037. [Google Scholar] [CrossRef] [PubMed]
- Gautam, A.; Beiss, V.; Wang, C.; Wang, L.; Steinmetz, N.F. Plant Viral Nanoparticle Conjugated with Anti-PD-1 Peptide for Ovarian Cancer Immunotherapy. Int. J. Mol. Sci. 2021, 22, 9733. [Google Scholar] [CrossRef]
- Zhang, W.; Cao, S.; Liang, S.; Tan, C.H.; Luo, B.; Xu, X.; Saw, P.E. Differently Charged Super-Paramagnetic Iron Oxide Nanoparticles Preferentially Induced M1-Like Phenotype of Macrophages. Front. Bioeng. Biotechnol. 2020, 8, 537. [Google Scholar] [CrossRef]
- Tseng, S.J.; Liao, Z.X.; Kao, S.H.; Zeng, Y.F.; Huang, K.Y.; Li, H.J.; Yang, C.L.; Deng, Y.F.; Huang, C.F.; Yang, S.C.; et al. Highly specific in vivo gene delivery for p53-mediated apoptosis and genetic photodynamic therapies of tumour. Nat. Commun. 2015, 6, 6456. [Google Scholar] [CrossRef]
- Tseng, S.J.; Huang, K.Y.; Kempson, I.M.; Kao, S.H.; Liu, M.C.; Yang, S.C.; Liao, Z.X.; Yang, P.C. Remote Control of Light-Triggered Virotherapy. ACS Nano 2016, 10, 10339–10346. [Google Scholar] [CrossRef] [PubMed]

Publisher’s Note: MDPI stays neutral with regard to jurisdictional claims in published maps and institutional affiliations. |
© 2021 by the authors. Licensee MDPI, Basel, Switzerland. This article is an open access article distributed under the terms and conditions of the Creative Commons Attribution (CC BY) license (https://creativecommons.org/licenses/by/4.0/).
Share and Cite
Liao, Z.-X.; Ou, D.-L.; Hsieh, M.-J.; Hsieh, C.-C. Synergistic Effect of Repolarization of M2 to M1 Macrophages Induced by Iron Oxide Nanoparticles Combined with Lactate Oxidase. Int. J. Mol. Sci. 2021, 22, 13346. https://doi.org/10.3390/ijms222413346
Liao Z-X, Ou D-L, Hsieh M-J, Hsieh C-C. Synergistic Effect of Repolarization of M2 to M1 Macrophages Induced by Iron Oxide Nanoparticles Combined with Lactate Oxidase. International Journal of Molecular Sciences. 2021; 22(24):13346. https://doi.org/10.3390/ijms222413346
Chicago/Turabian StyleLiao, Zi-Xian, Da-Liang Ou, Ming-Jung Hsieh, and Chia-Chen Hsieh. 2021. "Synergistic Effect of Repolarization of M2 to M1 Macrophages Induced by Iron Oxide Nanoparticles Combined with Lactate Oxidase" International Journal of Molecular Sciences 22, no. 24: 13346. https://doi.org/10.3390/ijms222413346
APA StyleLiao, Z.-X., Ou, D.-L., Hsieh, M.-J., & Hsieh, C.-C. (2021). Synergistic Effect of Repolarization of M2 to M1 Macrophages Induced by Iron Oxide Nanoparticles Combined with Lactate Oxidase. International Journal of Molecular Sciences, 22(24), 13346. https://doi.org/10.3390/ijms222413346

